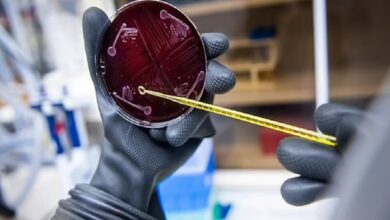

برچسبها: میکروبیوم روده باکتری سلول پروتئین
- اسلاید

ساخت نخستین نمونه میکروبیوم انسانی در آزمایشگاه
نخستین نمونه میکروبیوم انسانی که از ترکیب ۱۱۹ باکتری در آزمایشگاه ساخته شده است، میتواند روشی برای مقابله با عفونتهای…
بیشتر بخوانید »
نخستین نمونه میکروبیوم انسانی که از ترکیب ۱۱۹ باکتری در آزمایشگاه ساخته شده است، میتواند روشی برای مقابله با عفونتهای…
بیشتر بخوانید »